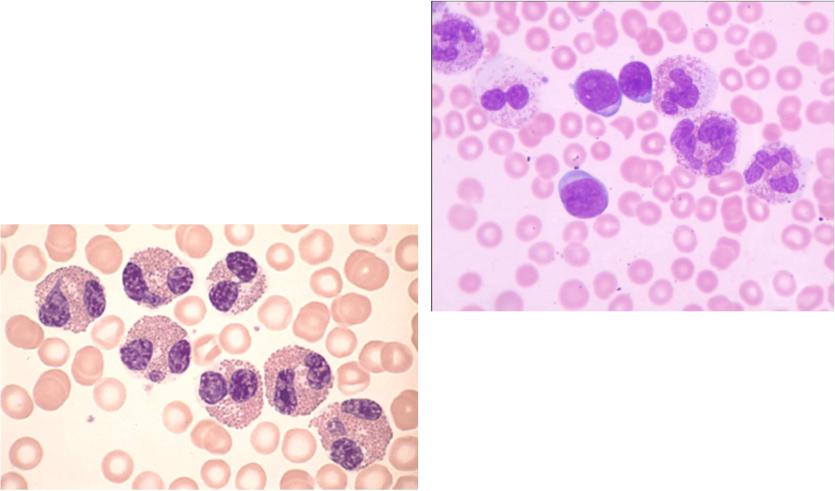

Материал: клинический+анализ+крови+3
Оценка клинического анализа крови
Раздел 3

Гранулоциты – лейкоциты, имеющие в цитоплазме специфическую зернистость
Сегментоядерный нейтрофил |
Сегментоядерный эозинофил |
Лимфоцит
Сегментоядерные базофилы
Различная окраска обусловлена цветом предметного стекла

Схема нейтрофилопоэза, нейтрофильные
сдвиги (см.также следующий слайд)
В крови циркулируют палочкоядерные и сегментоядерные нейтрофилы, ядра последних обычно состоят из 3-4 сегментов.
Нейтрофильный сдвиг вправо – это увеличение количества сегментов в ядре. Критерий сдвига вправо: на 100 нейтрофилов 3 клеток с 5 сегментами в ядре или хотя бы один нейтрофил с 6 сегментами.
Можно использовать формулу:
(Barbara J Bain. Interactive Haematology Imagebank with Assessement)
Нейтрофильный сдвиг влево – это увеличение в лейкоцитарной формуле количества палочкоядерных нейтрофилов и (или) появление ещё более незрелых нейтрофилов (метамиелоцитов, миелоцитов, промиелоцитов). Нейтрофильный сдвиг влево наблюдается при хроническом миелолейкозе, остром бактериальном воспалении, опухолях (особенно в случае метастазов в костный мозг).

Нейтрофильные сдвиги
миелобласт |
промиелоцит |
миелоцит |
метамиелоцит, |
или юный |
палочкоядерный |
сегментоядерные
Для невинной аномалии Пельгера характерно преобладание нейтрофилов с двухсегментными ядрами и увеличение числа палочкоядерных (ложный сдвиг влево). Наблюдаются случаи, когда сегментации ядер не происходит, хотя они имеют «зрелую» структуру хроматина. Знание этой аномалии очень важно для острой инфекционной, в т.ч. хирургической патологии.
Эозинофилия крови(более1 тыс./мкл)
наблюдается при
•паразитарных болезнях
•аллергических реакциях
•гемобластозах, редко при раках
•васкулитах
•бронхиальной астме
•некоторых кожных заболеваниях
|
Большая эозинофилия у пациента с |
|
ОЛЛ В2. Отмечается гипогрануляр- |
|
ность и неправильная сегментация |
|
ядер. |
Большая эозинофилия при |
В центре 3 лимфобласта. |
|
|
остром описторхозе |
|